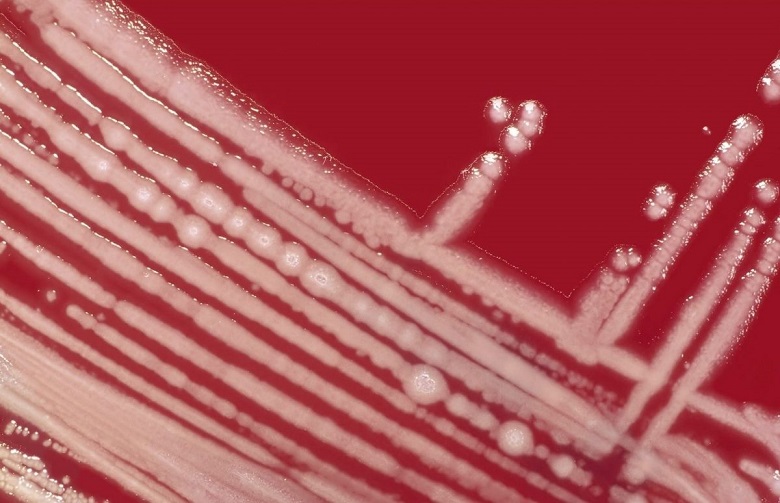

O universo microscópico de hospitais, muitas vezes invisível, pode estar revelando alianças inesperadas. Uma pesquisa da Universidade Federal do Rio Grande do Norte (UFRN), publicada no periódico Frontiers in Fungal Biology, traz à tona uma nova descoberta. De acordo com o estudo, a bactéria Pseudomonas aeruginosa, já conhecida por causar infecções graves, pode, na verdade, ter um papel benéfico ao inibir o crescimento do Candida auris, o superfungo multirresistente que desafia a medicina.
A pesquisa, fruto do trabalho de cientistas como Ana Beatriz Macedo, Danielle Figueredo e o professor Rafael Wesley Bastos, do Departamento de Microbiologia e Parasitologia da UFRN e do Grupo de Estudo de Ações em Saúde Única (GEASU-RN), abre uma frente de estudo importante sobre a dinâmica entre microrganismos. “Candida auris foi incluída pela OMS na lista de patógenos fúngicos prioritários”, afirma Rafael Bastos ao explicar sua gravidade. A Organização Mundial da Saúde (OMS) construiu essa lista como esforço global para identificar e classificar os fungos que representam maior ameaça à saúde pública mundial.

A bactéria Pseudomonas aeruginosa, por sua vez, é igualmente uma das principais causas de infecções hospitalares, sendo capaz de sobreviver em ambientes úmidos e formar biofilmes. Ambos podem coexistir em pacientes, o que torna a descoberta de sua interação ainda mais relevante.
Para desvendar esse fenômeno, a equipe utilizou uma metodologia baseada em experimentos de cultivo onde a bactéria e o fungo foram colocados para crescerem juntos em laboratório. Por meio de técnicas avançadas, como a microscopia de fluorescência, que diferencia células vivas de mortas, a pesquisa confirmou que a P. aeruginosa não mata o fungo, mas freia seu avanço, em um efeito que os cientistas classificam como fungistático. O estudo mostrou ainda que o fenômeno acontece por meio de moléculas secretadas pela bactéria.

Uma das revelações mais interessantes é o papel do ferro nesse antagonismo. Segundo Rafael Bastos, a “briga por ferro” é um mecanismo de defesa comum em nosso organismo contra patógenos. O que a pesquisa da UFRN demonstra é que essa mesma disputa parece acontecer entre os microrganismos. “A P. aeruginosa parece secretar alguma substância que indisponibiliza o ferro do meio de cultura para C. auris, impedindo seu crescimento”, detalha. A adição de mais ferro no meio de cultura foi capaz de reduzir a inibição, reforçando essa hipótese, embora não a elimine por completo, sugerindo que outros mecanismos também estão em jogo.

O estudo não apenas amplia a compreensão das interações microbianas, mas também aponta para direções futuras de pesquisa e o potencial para novas terapias. A equipe agora se dedica a identificar e caracterizar quimicamente as moléculas responsáveis pela inibição, além de investigar o fenômeno em modelos mais próximos da realidade clínica. O professor destaca que a pesquisa pode inspirar novas estratégias de biocontrole ou uso de metabólitos bacterianos como antifúngicos alternativos. Uma promessa significativa na luta contra as infecções hospitalares.
Leia a pesquisa completa neste link.
Fonte: Agecom/UFRN

![[VÍDEO] Operação da Polícia Civil cumpre 70 mandados contra facções criminosas no RN](https://www.jolrn.com.br/wp-content/uploads/2026/04/IMG_6096-120x86.png)





